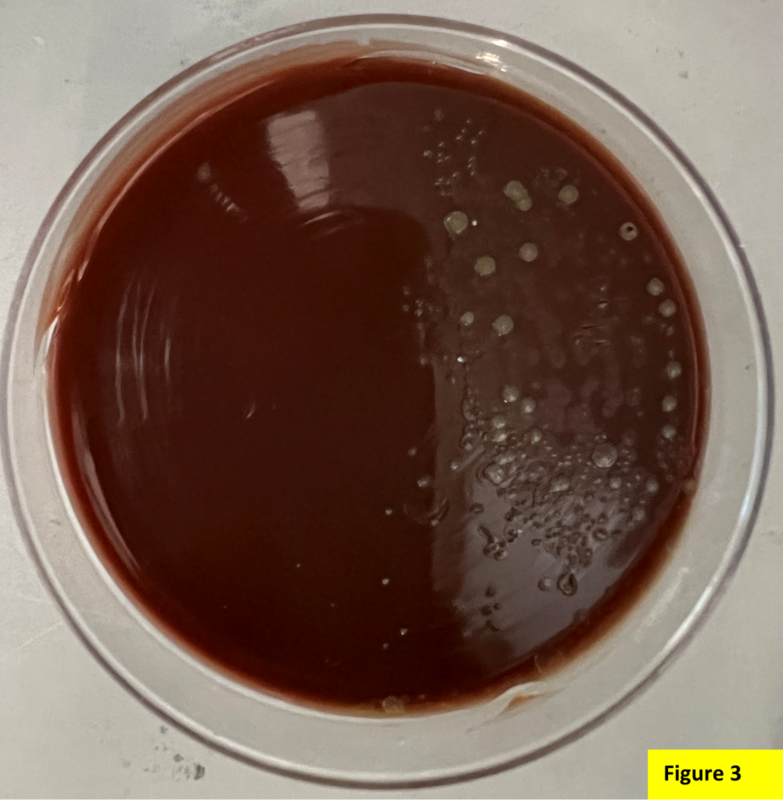

Девочка 13 лет обратилась к врачу в связи с болезненной припухлостью большого пальца левой руки.
Восемь дней назад она вырвала заусенец с медиальной стороны большого пальца левой руки, в результате чего возникла боль и образовался отек. Пять дней назад она обратилась в клинику, где ей прописали аугментин, но улучшения не наступило. Физикальное обследование показало нежную окружную припухлость большого пальца правой руки за пределами сгибательного сустава, с паронихией длиной 1 см с флюктуацией еще на 0,5 см. Рана была иссечена и дренаж был отправлен в микробиологическую лабораторию для получения культуры.
После 24 часов инкубации в культуре выросли грамотрицательные бациллы (илл. 1). В культуре выросло умеренное количество мелких негемолитических колоний, которые имели вид "точек" на кровяном (илл. 2) и шоколадном (илл.) агарах. Колонии имели заметный затхлый запах. На агаре МакКонки роста не было.

Идентификация методом масс-спектрометрии MALDI-ToF выявила Eikenella corrodens.
Обсуждение
Eikenella corrodens - это факультативно анаэробная, грамотрицательная, оксидаза положительная, каталаза отрицательная, неподвижная, не образующая спор палочка. Она относится к группе HACEK и входит в семейство Neisseriaceae. Является частью нормальной флоры полости рта и верхних дыхательных путей.
E. corrodens является оппортунистическим патогеном, который может привести к различным инфекциям, включая разнообразные инфекции головы и шеи (глазные, челюстные, щитовидной железы), плевропульмональные инфекции, инфекции кожи и мягких тканей и т.д.). Она может вызывать подкожные абсцессы и бактериемию у потребителей внутривенных наркотиков. E. corrodens также вызывает инфекции кисти (например, остомиелит) из-за хронического обкусывания ногтей, укуса человека или травмы. Бактерия может попасть в центральную нервную систему в результате инфекций пародонта, среднего уха или синусов и вызвать менингит, абсцесс мозга или спинного мозга, субдуральную эмпиему и остеомиелит. У некоторых предрасположенных лиц могут также возникать эндокардит и бактериемия.
В аэробных условиях эта бактерия медленно растет на кровяном и шоколадном агаре при температуре 35-37℃ и не растет на агаре МакКонки. Он образует маленькие, выпуклые, круглые или неправильной формы, серые и негемолитические колонии. Большинство изолятов могут "изъязвлять" агар, хотя как изъязвляющие, так и не изъязвляющие штаммы имеют сходные биохимические характеристики. Большинство штаммов имеют затхлый запах.
E. corrodens обычно чувствительна к ампициллину, амоксициллину, цефалоспоринам второго и третьего поколения, тетрациклинам, азитромицину, сульфаметоксазолу и фторхинолонам. Эти бактерии устойчивы к клиндамицину, ванкомицину, эритромицину, метронидазолу, аминогликозидам и пенициллиназоустойчивым пенициллинам, причем чувствительность к пенициллину варьирует от штамма к штамму. В лабораториях клинической микробиологии рутинное тестирование чувствительности к противомикробным препаратам для E. corrodens обычно не проводится, поскольку она обычно реагирует на бета-лактамы. При необходимости, можно провести тест на чувствительность.
Спектр заболеваний, вызываемых E. corrodens, расширяется, и важно изучить его клинические характеристики для своевременной диагностики и эффективного лечения.
